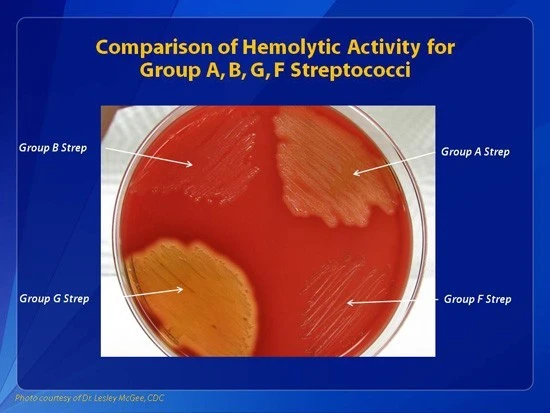
b_0f5Ud018svcij1eqtr3zeni_q49c4t.jpg?type=e1920_std

사랑스러운 자매와의 영원한 이별
[작은 아씨들] 속 성홍열(Scarlet fever)
‘작은 아씨들(Little Women)’은, 미국의 작가인 루이자 메이 올코트(Louisa May Alcott, 1832-1888)가 1868년에 출간한 소설입니다. 워낙 유명하고 인기 있는 소설이라 여러 차례 영화화되기도 하였고, 애니메이션으로 만들어진 적도 있습니다.
 작은 아씨들을 영상화한 작품들. 1987년 판 일본 애니메이션(좌), 1994년에 만들어진 영화(중간), 그리고 가장 최근 작품인 2019년도 영화(우).
작은 아씨들을 영상화한 작품들. 1987년 판 일본 애니메이션(좌), 1994년에 만들어진 영화(중간), 그리고 가장 최근 작품인 2019년도 영화(우).이 소설은 남북전쟁 시기인 1860년대의 미국 북부 매사추세츠 주의 작은 마을을 배경으로 하여, 목사 아버지를 둔 중산층 가정 안에서 성장하는 네 자매의 이야기를 다루고 있습니다.
평범하고 소박한 집안 분위기 안에서, 네 명의 소녀가 성장하는 모습이 따뜻하면서도 유머러스하게 그려져 있기 때문에, 이 책을 읽다 보면 실제 존재하는 자매들의 모습을 지켜보는 기분이 들기도 합니다.
 작은 아씨들 영화(2019). 보통 아버지는 남북전쟁 참전 중에 부상을 입었다는 설정으로 인해 잘 등장하지 않아 어머니와 네 자매가 주로 나옵니다.
작은 아씨들 영화(2019). 보통 아버지는 남북전쟁 참전 중에 부상을 입었다는 설정으로 인해 잘 등장하지 않아 어머니와 네 자매가 주로 나옵니다.
[작은 아씨들]의 가장 큰 매력은, 네 명의 자매가 지니고 있는 개성이 매우 뚜렷하다는 점입니다.
첫째인 메그(Meg, 마거릿의 애칭)는 자매 중에서 가장 아름다운 외모와 차분한 성격을 지닌 소녀로, 장녀답게 책임감이 강하지만 그 나이 또래 소녀답게 부잣집을 동경하는 허영심도 함께 가지고 있습니다. 글을 읽다 보면 19세기 말이라는 시대가 요구하는 참한 여성상이 메그가 아니었을까란 생각이 들기도 하였습니다. 어쨌든 메그는 결국 부유함보다는 사랑을 택하여 약간은 가난하지만 단란한 가정을 꾸리게 됩니다.
 결국 이웃집에서 일하는 가정교사와 결혼하는 메그.
결국 이웃집에서 일하는 가정교사와 결혼하는 메그.
둘째인 조(Jo, 조세핀의 애칭)는 어찌 보면 가장 ‘신여성’같은 스타일로, 털털하고 말괄량이 같은 성격을 지닌 작가 지망생 소녀입니다.
상상력이 풍부하고 행동력이 넘치기에 소설 속 네 자매 중에서도 가장 주인공처럼 느껴집니다. 작가가 되고 싶다는 꿈을 쫓아 노력하는 멋진 여장부스러운 모습을 보여주기도 하지만, 이웃 부잣집(로렌스 가문) 소년인 로리와의 우정 이상, 사랑 미만의 묘한 기류를 형성하는 역할도 맡고 있습니다.
 둘째인 조와 이웃집 소년인 로리.
둘째인 조와 이웃집 소년인 로리.
셋째인 베스(Beth, 엘리자베스의 애칭)는 가장 상냥하고 수줍음 많은 성격을 지닌 소녀로, 몸이 허약하여 집에서 공부를 지내고 있습니다.
피아노 연주에 재능이 있어, 로렌스 가문의 피아노를 치게 되어 기뻐하는 모습을 보여주기도 합니다. 자매들 중에서 가장 온화하여, ‘마치 가족의 평화의 수호자’ 같은 역할을 맡고 있습니다. 워낙 다정하고 동정심이 많아 같은 마을에 사는 가난한 ‘훔멜 집안’의 어린 아이가 병에 걸리자 헌신적으로 간호해주기도 하죠. 제 개인적으로 가장 좋아하던 캐릭터이기도 했습니다.
 어떤 영상화된 작품 속에서도 가장 얌전하고 온화한 모습으로 등장하는 베스. 병약하지만 다정한 성격이라 '천사'같다는 표현도 나옵니다.
어떤 영상화된 작품 속에서도 가장 얌전하고 온화한 모습으로 등장하는 베스. 병약하지만 다정한 성격이라 '천사'같다는 표현도 나옵니다.
넷째인 에이미는 정말 막내다운 성격을 가지고 있는, 귀엽지만 고집 있는 소녀입니다. 금발에 푸른 눈을 지닌 요정 같은 외모지만, 코가 살짝 낮은 게 고민이라 자기 전에 빨래 집개로 코를 집고 자는 행동을 반복하기도 하고 학교에 몰래 간식을 들고 갔다가 크게 혼나는 등, 응석받이 막내의 전형을 보여주는 모습들이 묘사됩니다.
둘째 언니인 조가 연극 공연에 데려가 주지 않는 것에 화가 나서, 언니가 쓴 소중한 소설 원고를 다 태워버리고 크게 싸우는 모습을 보면, 현실 속 형제자매 싸움처럼 느껴집니다. 다시는 서로 안 볼 것처럼 싸웠다가 ‘특별한 계기’로 인해 극적으로 화해하는 과정도 매우 현실 자매 같죠.
 2019년 영화 속에서 조의 원고를 태우는 에이미. 자매 싸움의 절정으로 치닫는 장면이라할 수 있습니다.
2019년 영화 속에서 조의 원고를 태우는 에이미. 자매 싸움의 절정으로 치닫는 장면이라할 수 있습니다.
실제로 이 소설은 반쯤은 작가의 자전적인 소설이라고 볼 수도 있는데, 작은 아씨들 안에 작가인 루이자 메이 올코트의 가정사가 투영되어 있기 때문입니다.
작가의 아버지인 아모스 브론슨 알코트(Amos Bronson Alcott)은 철학자이자 교육자였는데, 소설 속의 아버지보다 훨씬 더 검소와 절제를 강조했기에, 루이자가 자신의 아버지를 존경은 했어도 편하게 느끼진 못했던 것으로 여겨집니다. 아마 자신의 아버지에게서 충분하게 받지 못했던 다정함과 포용력을 소설 속의 온화하고 이해심 많은 아버지에게 부여했던 것이 아닐까 싶습니다.
 루이자 메이 올코트의 실제 아버지인 아모스 브론슨 알코트의 사진.
루이자 메이 올코트의 실제 아버지인 아모스 브론슨 알코트의 사진.소설 속 네 자매들처럼, 루이자에게도 위로는 언니, 아래로는 두 명의 동생으로 이루어진 자매가 있었습니다. 루이자가 [작은 아씨들] 속의 둘째이자 작가 지망생으로 나오는 ‘조(Jo)’에게 본인의 모습을 담았을 것이라는 것을 알 수 있죠.
 작은 아씨들의 작가인 루이자의 20세 때 모습(좌). 2019년도 영화 속에 등장하는 조의 모습(우).
작은 아씨들의 작가인 루이자의 20세 때 모습(좌). 2019년도 영화 속에 등장하는 조의 모습(우).
[작은 아씨들] 속의 가장 슬픈 사건 역시, 루이자가 실제 겪었던 일을 바탕으로 만들어진 것으로 생각됩니다. 그 사건이란 바로, 자매 중 셋째인 ‘베스’의 죽음이죠.
자매들끼리 사이 좋게, 혹은 투닥거리기도 하면서 평온하게 살아가던 마치 집안에 비극이 그림자를 드리우게 되는 까닭은, 앞서 잠시 언급했던 ‘베스가 훔멜 집안의 어린 아이(‘baby’라고 표현되는 것으로 보아 굉장히 어린)를 돌봐 주던 일’과 관련이 있습니다.
이 아이는 성홍열(Scarlet fever)이란 병에 걸린 상태였는데, 베스가 아이를 헌신적으로 간호하다가 감염되고 말았던 것입니다.
베스는 성홍열로 인한 고열 등의 증상으로 고생하다가 처음에는 어느 정도 회복하는 듯이 보였습니다. 그러나 결국 몸이 매우 약해진 상태로 지내다가 3년 정도 지나서 사망하게 됩니다. 베스의 죽음에 대한 내용은 작가의 여동생인 리지(Lizzie, 이 여동생의 실제 이름도 엘리자베스였습니다)가 성홍열 감염 후유증으로 인해 22세에 요절하게 된 상황과 매우 흡사합니다.
 루이자의 동생이자 소설 속 베스처럼 성홍열로 요절한, 엘리자베스 슈웰 올코트의 사진.
루이자의 동생이자 소설 속 베스처럼 성홍열로 요절한, 엘리자베스 슈웰 올코트의 사진.
저는 [작은 아씨들]이란 책을 10대 초반에 처음 접했었는데, 가장 좋아하던 캐릭터인 베스가 죽는 모습에 상당한 충격을 받았었습니다.
소설 속에서 너무나도 상냥하고 다정하던 소녀가 어린 나이에 속절 없이 죽게 되는 상황이 너무 안타까워서 ‘성홍열’이란 병명이 뇌리에 박힐 정도였으니까요.
그리고 의대에 와서 성홍열, Scarlet fever라는 질병이 무엇인지 정확히 알게 되었고, 이 병에 대해 알게 되자 왜 베스가 처음 감염에서 회복되고도 쇠약해지고 3년 후에 사망하게 된 까닭을 이해할 수 있었습니다.
 쇠약해진 베스의 모습. 1994년도 영화.
쇠약해진 베스의 모습. 1994년도 영화.
성홍열은 A군 베타 용혈성 연쇄구균(Group A β-hemolytic Streptococci)이란 세균에 의해 발생하는 급성 감염성 질환으로, 고열(섭씨 38도 이상), 인후통, 복통, 그리고 전신에 나타나는 발진을 특징으로 합니다.
특히 전신적으로 발생하는 발진이 병명인 ‘성홍열’에 맞게 아주 붉게 나타나는데, 보통 얼굴과 목에서 시작되어 몸통과 팔/다리로 퍼져 나가는 양상을 보입니다. 팔목, 무릎, 목, 사타구니와 같이 피부가 접히는 곳은 더욱 진하고 어두운 색의 붉은 색으로 보이게 되죠.
혀는 질병 초기에 회백색으로 코팅된 것처럼 보이다가 점차 아주 붉고 울퉁불퉁한 모습을 보여서 ‘딸기혀(Strawberry tongue)’라고 부르기도 합니다.
 성홍열의 증상들. 전신 발진(좌)과 딸기혀(우).
성홍열의 증상들. 전신 발진(좌)과 딸기혀(우).
임상 증상이 독특하지만, 다른 질환과의 감별(풍진이나 약물 유발성 발진 등)이 필요할 수 있고, 현대에는 편도나 인두에서 균을 채취하여 배양 검사를 하거나, 혈액에서 항원을 검출하는 방법 등을 통해 정확한 진단을 내릴 수 있습니다.
 연쇄상구균 배양. 배지 안에서 오른쪽 윗부분이 A군 연쇄상구균이 배양된 모습입니다. 출처: https://www.cdc.gov/groupbstrep/lab/index.html
연쇄상구균 배양. 배지 안에서 오른쪽 윗부분이 A군 연쇄상구균이 배양된 모습입니다. 출처: https://www.cdc.gov/groupbstrep/lab/index.html
이 질환은 5~15세 사이의 어린이들에게 가장 잘 발생하지만, 영유아에게도 발생할 수 있으며 성인도 감염될 수 있습니다.
예방을 위해서는 손을 잘 씻고, 환자와 식기 등을 공유하지 않도록 주의하며, 기침이나 재채기를 통해 균이 퍼지는 것을 막기 위해 환자에게 마스크를 쓰도록 하는 것이 필요합니다.
치료는 페니실린(Penicillin)이나 아목시실린(amoxicillin)과 같은 항생제를 투여하고, 아세타아미노펜 등으로 발열과 인후통을 조절하는 방식으로 진행됩니다.
현대에는 항생제 사용을 통해 굉장히 잘 치료되는 병이지만, 여러 가지 사정으로 충분한 치료를 받지 못할 경우에는 류마티스 열(Rheumatic fever)로 이어져, 심장, 관절, 피부, 신경계 등에 영향을 주는 심각한 염증성 질환으로 악화될 수 있습니다.
소설 속 베스는 간호를 위해 성홍열에 걸린 아이와 많은 접촉을 했고, 현대와 같은 의학 지식이 없었기에 손씻기나 마스크 쓰기 등의 예방 조치를 취하지 못했기에 성홍열에 감염이 되었던 것으로 생각됩니다.
그리고 성홍열 특유의 고열과 발진 등의 증상에 시달리다가 처음엔 회복했지만, 결국 항생제 치료 등을 받지 못했기에(페니실린은 베스가 살던 시대로부터 60년 정도 지난 시기인 1928년에 발견), 류마티스성 심장 질환(Rheumatic heart disease-보통 심장 판막에 이상이 생기는)이라는 후유증이 발생한 것으로 보입니다. 그래서 끊임없이 쇠약해지다가 결국 3년이 지나 사망에 이르게 된 것이죠.
 류마티스성 심장 질환. 오른쪽 원안의 그림이 망가진 심장 판막의 모습. 심부전이나 심내막염 등을 일으킬 수 있으며, 심장 판막의 손상이 심각할 경우에는 수술이 필요합니다.
류마티스성 심장 질환. 오른쪽 원안의 그림이 망가진 심장 판막의 모습. 심부전이나 심내막염 등을 일으킬 수 있으며, 심장 판막의 손상이 심각할 경우에는 수술이 필요합니다.
루이자는 자신의 동생인 리지의 성홍열 감염과 후유 증상에 의한 사망을 지켜보았기에, 소설 속 베스의 죽음도 표현할 수 있었던 것 같습니다.
의료인이 아니었던 루이자가 ‘성홍열’이란 질환을 언급하고 후유증으로 사망하는 상황(일반적인 경우라면 고열과 붉은 발진이 나는 급성 감염 상태까지만 들어본 적이 있을 것입니다)까지 소설 속에 표현할 수 있었던 것은 가족의 죽음을 지켜볼 수 밖에 없었던 안타까운 경험이 있었기 때문이죠.
[작은 아씨들]은 19세기를 배경으로 한 소설이지만, 가족 간의 사랑과 개성 넘치는 소녀들의 성장기를 보여준다는 점에서 언제 읽어도 재밌고 마음이 포근해집니다. 그러나 의사의 관점에서는 지금은 치료할 수 있는 병으로 죽어가야 했던 베스와 이름 모를 아기의 사연이 참 안타깝게 느껴집니다. 아마 이 소설이 21세기에 쓰여졌다면, 베스도 성홍열에서 잘 회복되어 다른 자매들과 함께 울고 웃으며 멋진 어른으로 성장해나가는 모습을 보여주었을 것입니다.
소설 속의 베스는 영원히 가족들과 영원히 이별하게 되었지만, 21세기를 살아가는 작은 아씨들은 모두 건강하고 행복하기를 바래봅니다.